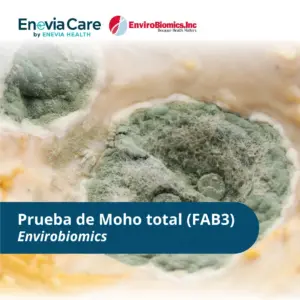
Prueba de Moho total (FAB3) - Envirobiomics

Pruebas más vendidas
-
Prueba de Moho total (FAB3) – Envirobiomics
€267,00 - €312,00Rango de precios: desde €267,00 hasta €312,00 Seleccionar opciones Este producto tiene múltiples variantes. Las opciones se pueden elegir en la página de producto -

Prueba ERMI – Envirobiomics
€267,00 - €312,00Rango de precios: desde €267,00 hasta €312,00 Seleccionar opciones Este producto tiene múltiples variantes. Las opciones se pueden elegir en la página de producto -

Prueba HERTSMI-2 – Envirobiomics
€145,00 - €169,00Rango de precios: desde €145,00 hasta €169,00 Seleccionar opciones Este producto tiene múltiples variantes. Las opciones se pueden elegir en la página de producto -

Test de Ácidos Orgánicos (OAT) – Mosaic Diagnostics
€274,00 Añadir al carrito -

Test de Ácidos orgánicos OAT – Diagnostic Solutions
€205,00 Añadir al carrito -

Test de Metabolómica Orgánica OMX – Diagnostic Solutions
€231,00 Seleccionar opciones Este producto tiene múltiples variantes. Las opciones se pueden elegir en la página de producto -

Test de Metilación de ADN – Doctors Data
€543,00 Seleccionar opciones Este producto tiene múltiples variantes. Las opciones se pueden elegir en la página de producto -

Test de Microbioma – Biomesight
€218,00 Añadir al carrito -

Test de mitocondrias y microbiota – Test EBA – Pronacera
€1.204,00 Añadir al carrito -

Test de respuesta de citoquinas CytoDX – Diagnostic Solutions
€231,00 Añadir al carrito
¿No encuentras la prueba que estas buscando o no esta disponible para la compra en tu país?
Si no encuentras la prueba que estas buscando o no esta disponible en tu país puedes escribir a nuestro departamento de ventas a traves de WhatsApp
O si lo prefieres, déjanos tus datos y nos pondremos en contacto contigo para resolver tus dudas. ¡Gracias!